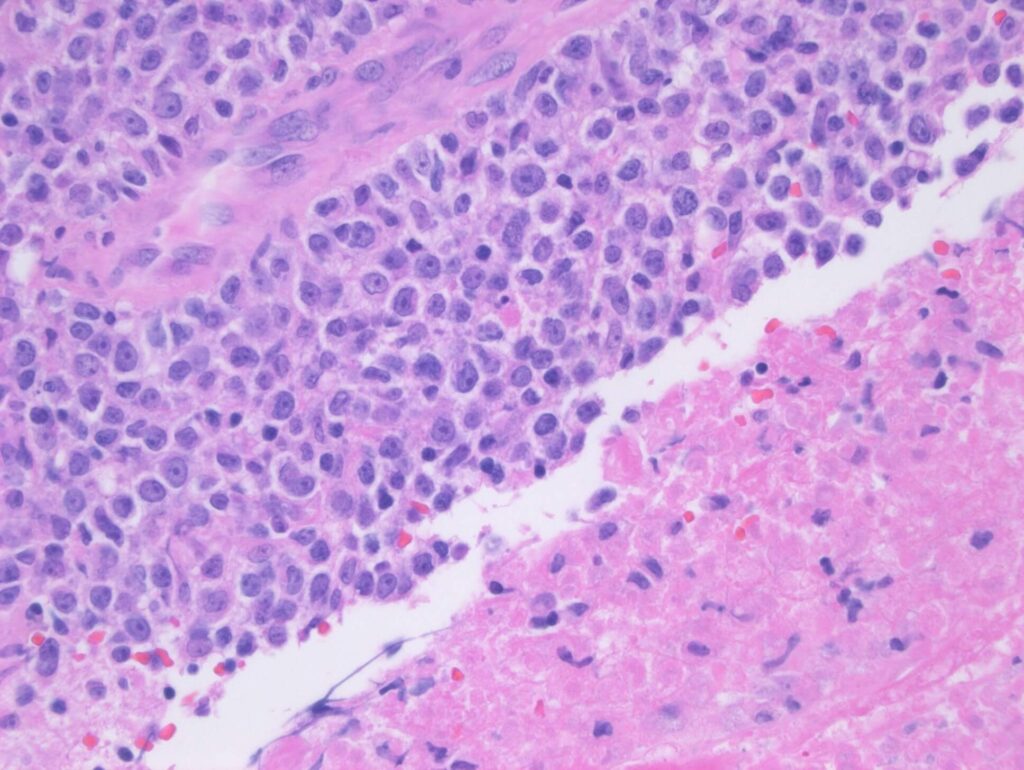

Imaging appearances of a rare CNS disease by MRI
Central nervous system post-transplant lymphoproliferative disorder is a rare disease with non-specific signs and symptoms. Due to its rarity and lack of radiologists’ familiarity with it, this paper presents how the imaging appearances of this disease by MRI can help in attempting to narrow the differential diagnosis, facilitate the diagnostic work-up and optimize delivering the diagnosis.
Central nervous system post-transplant lymphoproliferative disorder is a rare disease with non-specific signs and symptoms. Due to its rarity and lack of radiologists’ familiarity with it, this paper presents how the imaging appearances of this disease by MRI can help in attempting to narrow the differential diagnosis, facilitate the diagnostic work-up and optimize delivering the diagnosis.
Authors: Matthew L. White, Drew W. Moore, Yan Zhang, Keiper D. Mark, Timothy C. Greiner and Philip J. Bierman